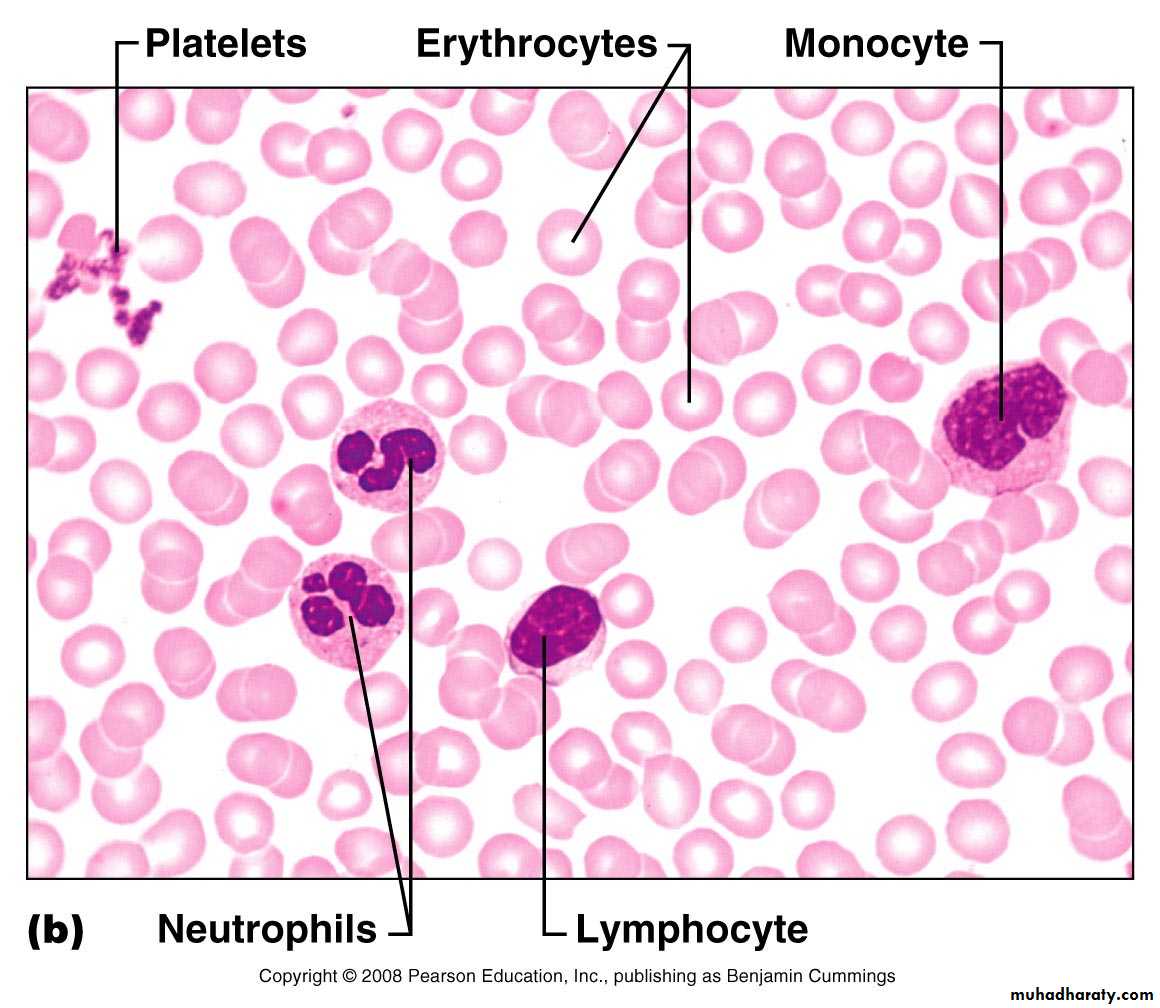
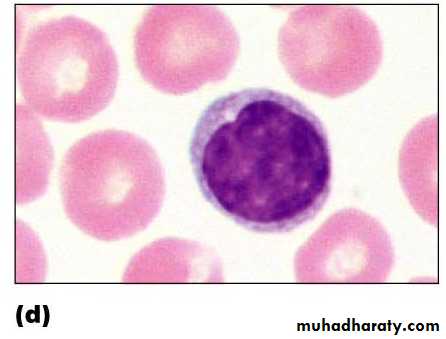

BLOOD
Provides a mechanism for rapid transport of nutrients, waste products, respiratory gases and cells
Powered by the pumping action of the heart
Introduction
Cardiovascular SystemSystem made up of blood vessels, blood and heart. Major function is to transport nutrients, gases and hormones to the cells and pick up wastes from cells to transport them to areas of body where they are excreted
Lymphatic System
Network of vessels that return the fluid escaped from blood vessels back to the bloodstream. Includes lymphocytes, lymphoid tissue and lymphoid organs which fight infections and give immunity to disease
Circulatory System
Together the cardiovascular system and lymphatic system make up the circulatory system
Functions of blood
Transportation (dissolved gases, nutrients, hormones and metabolic wastes).
Protection - Platelets in the blood and clotting proteins minimize blood loss when a blood vessel is damaged.
Regulation
Blood regulates the pH and electrolyte composition of the interstitial fluids.
Blood regulates body temperature.
Composition Of Blood
A specialized connective tissue. Contains cellular and liquid componentsBlood cells : formed elements
Plasma : fluid portion and fibrinogen
Blood volume
Males: 5 – 6 liters
Females: 4 – 5 liters
The pH of blood is about 7.35-7.45
Blood Plasma
Straw-colored, sticky fluid portion of bloodApproximately 90% water
Contains:
Ions : Na+ and Cl-
Nutrients : sugars, amino acids, lipids, cholesterol, vitamins and trace elements
Three main proteins : Albumin (60%), globulin (35%), fibrinogen (4%)
Dissolved Gasses : including O2 and CO2
Waste Products : other protein wastes such as urea and bilirubin
Figure 19.1b
Composition of Whole Blood
Figure 19.1c
Composition of Whole BloodOverview: Composition of Blood
Hematocrit – measure of % RBCMales: 47% ± 5%
Females: 42% ± 5%
Figure 17.1
Wright’s Stain
Figure 17.2b
Erythrocytes – Red Blood Cells (RBCs)
Oxygen-transporting cells7.5 µm in diameter (diameter of capillary 8 – 10µm)
Most numerous of the formed elements
Females: 4.3 – 5.2 million cells/cubic millimeter
Males: 5.2 – 5.8 million cells/cubic millimeter
Made in the red bone marrow in long bones, cranial bones, ribs, sternum, and vertebrae
Average lifespan 100 – 120 days
RBC Structure And Function
Have no organelles or nucleiHemoglobin : oxygen carrying protein. Each RBC has about 280 million hemoglobin molecules
Biconcave shape – 30% more surface area
Leukocytes – White Blood Cells (WBCs)
Protect the body from infectious microorganisms
4,800 – 11,000/cubic millimeter
Function outside the bloodstream in loose connective tissue
Diapedesis (circulating leukocytes leave the capillaries)
WBCs have a nucleus and are larger than RBCs
Most produced in bone marrow
Lifespan of 12 hours to several years
Leukocytes – White Blood Cells (WBCs)
Two types of leukocytesGranulocytes
Agranulocytes
Figure 17.5
White Blood Cells
• Type Of White Blood Cells• % By Volume Of WBC
• Description
• Function
• Neutrophils
• 60 – 70 %
• Nucleus has many interconnected lobes; blue granules
• Phagocytize and destory bacteria; most numerous WBC
• Eosinophils
• 2 – 4 %
• Nucleus has bilobed nuclei; red or yellow granules containing digestive enzymes
• Play a role in ending allergic reactions
• Basophils
• < 1 %
• Bilobed nuclei hidden by large purple granules full of chemical mediators of inflammation
• Function in inflammation medication; similar in function to mast cells
• Lymphocytes (B Cells and T Cells)
• 20 – 25 %
• Dense, purple staining, round nucleus; little cytoplasm
• the most important cells of the immune system; effective in fighting infectious organisms; act against a specific foreign molecule (antigen)
• Monocytes
• 4 – 8 %
• Largest leukocyte; kidney shaped nucleus
• Transform into macrophages; phagocytic cells
Granulocytes
Neutrophils – most numerous WBC
Phagocytize and destroy bacteria
Nucleus – has two to six lobes
Granules pick up acidic and basic stains
Figure 17.4a
Eosinophils – compose 1 – 4% of all WBCs
Play roles in ending allergic reactions, parasitic infectionsFigure 17.4b
Granulocytes
Granulocytes
Basophils – about 0.5% of all leukocytesNucleus – usually two lobes
Granules secrete histamines
Function in inflammation mediation, similar in function to mast cells
Agranulocytes
Lymphocytes – compose 20 – 45% of WBCsThe most important cells of the immune system
Nucleus – stains dark purple
Effective in fighting infectious organisms
Act against a specific foreign molecule (antigen)
Two main classes of lymphocyte
T cells – attack foreign cells directly
B cells – multiply to become plasma cells that secrete antibodies
Figure 17.4d
Agranulocytes
Monocytes – compose 4–8% of WBCsThe largest leukocytes
Nucleus – kidney shaped
Transform into macrophages
Phagocytic cells
Figure 17.4e
Platelets
StructureSmall cellular fragments; originate in bone marrow from giant cell (megakaryocyte)
Contain several clotting factors (calcium ions, ADP, serotonin)
Function
Involved in stopping bleeding when a blood vessel is damaged; Process is called hemostasis
Blood Cell Formation
Hematopoiesis – process by which blood cells are formed100 billion new blood cells formed each day
Takes place in the red bone marrow of the humerus, femur, sternum, ribs, vertebra and pelvis
Red marrow – actively generates new blood cells
Contains immature erythrocytes
Remains in epiphyses, girdles, and axial skeleton
Yellow marrow – dormant
Contains many fat cells
Located in the long bones of adults
Tissue framework for red marrow
Reticular connective tissue